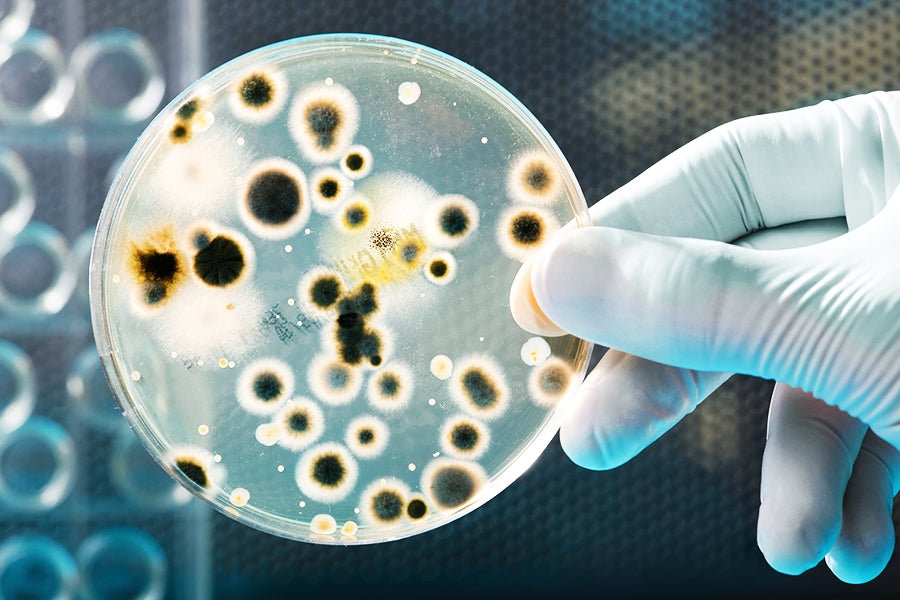

Protect your lungs by purifying the air you breathe whilst indoors. The wet and cold weather that is imminent means we stay tucked up inside where air-borne bacteria can thrive – especially harmful mould particles. Simply pop a tub of our unique evaporative gel by your office desk, or in your bedroom | bathroom | living areas. As the gel evaporates, any mould spores including E-Coli, Legionnaires and Golden Staph will be annihilated at the molecular cell level. All 100% natural.
Comments on post (0)
Leave a comment